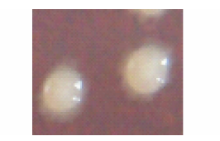
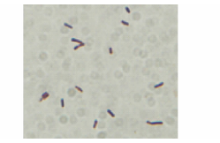

作者简介:冯中红(1991-),女,甘肃临夏人,在读硕士。E-mail:1142595813@qq.com*通讯作者Corresponding author. E-mail:yangcd@gsau.edu.cn
采用含菌平板抑菌圈测定法,从120株高寒草地牧草内生细菌中分离筛选到一株对番茄细菌性叶斑病拮抗能力较强的菌株264ZY7,其抑菌圈直径为1.22 cm。264ZY7菌体短杆状,大小为1.534 μm×0.571 μm~3.210 μm×0.781 μm,革兰氏阳性菌,根据形态特征,并结合16S rDNA和gyrB基因序列相似性分析,将菌株264ZY7鉴定为解淀粉芽孢杆菌 Bacillus amyloliquefaciens。通过室内盆栽防效试验,结果表明该菌株对番茄细菌性叶斑病的防效达69%,此外,该菌株对8种病原真菌具有抑菌能力,说明抑菌谱较宽,且抑菌率均大于30%,对番瓜根腐病菌( Fusarium sp.)效果最明显,抑菌率为52.84%。该研究结果为高寒草地紫花针茅内生细菌264ZY47的进一步开发利用提供了依据。
After screening by assessing inhibition zones on nutrient media an antagonistic endophytic bacteria, strain 264ZY7, was identified as having strong antagonistic ability against Pseudomonas syringe pv. tomato which causes bacterial spot on tomatoes. This strain was selected from 120 endophytic bacteria strains isolated from alpine meadow pasture. Strain 264ZY7 produced a 1.22 cm diameter inhibition zone. The bacteria is rod-shaped with a spore size of 1.534 μm×0.571 μm-3.210 μm×0.781 μm, gram-positive and was identified as Bacillus amyloliquefaciens based on morphology and homology analysis of the 16S rDNA and gyrB gene sequence. The control efficacy of strain 264ZY7 on bacterial spot on tomatoes grown in pots ranged up to 69%. It was also able to control fungal pathogens, in particular Fusarium sp. (52.84% efficacy). These results suggest that further development and utilization of this endophytic bacteria strain (264ZY7) should be undertaken.
番茄细菌性叶斑病(番茄细菌性斑点病)(Pseudomonas syringa pv. tomato)主要发生在番茄(Lycopersicon esculentum)、辣椒(Capsicum annuum)和茄子(Solanum melongena)等植物, 其自1933年首次报道以来, 在美国、英国、前苏联、加拿大、法国、南非和澳大利亚等26个国家和中国的台湾省都有发生[1]。Yunis和Crall[2]报道, 该病可造成番茄5%~75%的产量损失, Bonn 和 Martin[3]报道了美国部分州番茄受害情况, 番茄细菌性叶斑病我国最初只在台湾有记载[2], 后赵廷昌等[4]报道在吉林省、辽宁省、黑龙江省、河北省、甘肃省、新疆维吾尔自治区和天津市也有发生。近年来, 该病迅速蔓延, 在高温高湿条件下易流行, 一般发病率在40%以上, 严重时可达100%[5], 且严重度呈增长趋势。目前, 番茄细菌性叶斑病主要利用化学农药防治, 尽管有一定效果, 但化学防治会引起植物病原抗药性和农药残留等问题, 造成环境污染和生态破坏[6], 而生物防治既可取得良好的防治效果, 又能克服以上缺点, 已成为目前研究热点。植物病害生防菌主要从土壤或植物根际土壤微生物中分离筛选得到[7]。研究发现, 所有健康植物体内几乎都存在内生细菌[8], 且部分内生细菌具有良好的抑菌功能, 其开发为微生物农药后具有可能在植物体内长期定殖, 环境影响小和持效期长等优点。因此, 从植物内生细菌中筛选拮抗细菌进行生物防治被认为是最具发展潜力的防治方法之一[9]。本研究通过从东祁连山高寒草地牧草的根、茎、叶、花等部位分离的内生细菌中筛选了一株对番茄细菌性叶斑病菌具有较强拮抗作用的内生细菌, 对其拮抗能力和室内盆栽防治效果等进行了研究, 并进行了鉴定, 以期为进一步开发利用提供理论依据。
供试病原细菌:番茄细菌性叶斑病菌。
供试拮抗菌:采用常规分离法, 分离自东祁连山高寒草地紫花针茅(Stipa capillata)、线叶嵩草(Kobresia capillifolia)和矮生嵩草(Kobresia humilis)健康根、茎、叶、花部位的120株内生细菌。
供试病原真菌:马铃薯炭疽病菌(Colletotrichum coccodes)、马铃薯枯萎病菌(Fusarium avenaceum)、小麦根腐病菌(Bipolaris sorokiniana)、孜然根腐病菌(Fusarium solani)、黄瓜枯萎病菌(Fusarium oxysporum)、番瓜根腐病菌(Fusarium sp.)、番茄灰霉病菌(Botrytis cinerea)和马铃薯褐腐病菌(Stysanus stemonitis)。
以上均由甘肃农业大学草业学院植物病理学实验室提供。
肉汁胨培养基(NA)、PDA培养基, 方法见参考文献[10-11]。
采用含菌平板抑菌圈测定法[12], 在100 mL熔解后冷却至45℃左右的NA培养基中加入1 mL病原菌菌液(含菌量cfu/108 mL), 混匀后制成含菌平板, 然后在每个平板上分别均匀的接种120株拮抗菌株, 3次重复, 28℃恒温培养, 48 h后测量其抑菌透明圈大小并记录数据。
1.4.1 形态观察
将筛选得到的拮抗菌株接种于NA培养基上, 置于28℃培养箱中培养3 d后, 观察菌落的形态特征并描述; 将活化12 h后的拮抗菌株进行革兰氏染色[8], 观察菌体着色和测量菌体大小(30个), 并拍照。
1.4.2 分子生物学鉴定
1) 16S rDNA序列鉴定。拮抗菌株DNA采用Ezup柱式基因组DNA抽提试剂盒(上海生工生物有限公司)提取。16S rDNA的扩增利用通用引物27F和1492R[13]。PCR扩增条件为95℃预变性5 min, 94℃变性1 min, 48℃退火30 s, 72℃延伸1 min, 循环30次; 再在72℃下延伸8 min后终止反应。扩增反应体系总体积为50 μ L, 其中10× buffer 5 μ L, MgCl2(25 mol/L)3 μ L, dNTP(5 mmol/L)1 μ L, Taq聚合酶(5U/μ L)0.5 μ L, 27F(10 μ mol/L)1 μ L, 1492R(10 μ mol/L)1 μ L, Target DNA 1 μ L, ddH2O 47.5 μ L。经凝胶电泳检测后有特异性条带的扩增产物送生工生物(上海)有限公司进行测序。将测定的序列与在GenBank中已知的序列进行Blast同源性比对分析, 并用CLUSTALX 1.8进行多重序列比较, 最后用Mega 4.0软件邻接法构建系统发育树, 明确该拮抗菌株的系统发育学地位。
2) gyrB基因序列鉴定。由于细菌16S rDNA具有高度保守性[14], 在比较一些相似性比较高的近缘种时, gyrB基因更能准确的鉴定到种。拮抗菌株DNA的提取方法同1.4。以细菌gyrB基因扩增引物UP-1(5'-GAAGTCATCATGACCGTTCTGCATGCCGGTGGAAAGTTCGA-3')和引物UP-2(5'-AGCAGGGTACGGATGTGCGAGCCATCTACGTCAGCGTCAGTCAT-3')进行扩增[15]。扩增体系为10× PCR buffer 2.5 μ L, MgCl2(25 mol/L)2 μ L, dNTP(5 mmol/L)1 μ L, Taq酶(5 U/μ L)1 μ L, UP-1 1 μ L, UP-2 1 μ L, 模板DNA 1 μ L, ddH2O:15.5 μ L, 总体系为25 μ L。扩增条件:95℃预变性5 min; 94℃变性1 min, 55℃退火1 min, 72℃延伸2 min, 30个循环; 最后在72℃延伸10 min。
采用平板对峙法[13]测定抑菌效果。将直径5 mm供试病原真菌, 包括马铃薯炭疽病菌、马铃薯枯萎病菌、小麦根腐病菌、孜然根腐病菌、黄瓜枯萎病菌、番瓜根腐病菌、番茄灰霉病菌和马铃薯褐腐病菌菌饼置于PDA 平板中央, 与其四周2.5 cm处点接拮抗菌株264ZY7, 每处理重复3次, 于28℃培养箱中培养, 待对照指示菌满皿后测量菌落直径, 计算抑菌率。
抑菌率(%)=(对照的菌落直径-处理的菌落直径)/对照的菌落直径× 100
将拮抗菌和番茄细菌性叶斑病菌(病原菌)分别经摇瓶液体培养24 h后, 先将病原菌通过伤口接种法接种于健康的番茄植株叶片上, 24 h后再接种拮抗菌悬液, 保湿24 h后在室内条件下待其发病, 10 d后观察发病情况, 计算发病率、病情指数及拮抗菌对番茄叶斑病的相对防治效果。叶斑病病情指数分级标准为, 0级:叶片无病斑; 1级:0< 病斑面积占总叶片面积≤ 10%; 2级:10%< 病斑面积占总叶片面积≤ 25%; 3级:25%< 病斑面积占总叶片面积≤ 50%; 4级:50%< 病斑面积占总叶片面积≤ 75%; 5级:75%< 病斑面积占总叶片面积≤ 100%。计算方法[5]如下:
发病率=发病叶片数/调查总叶片数× 100%
病情指数=∑ (各级发病数× 各级代表值)/(调查总叶数× 最高代表值)× 100%
防病效果=(病原菌对照的病情指数-拮抗菌处理的病情指数)/病原菌对照的病情指数× 100%
从120株供试内生细菌中筛选出14株对番茄细菌性叶斑病菌有明显抑菌带或抑菌圈的拮抗细菌, 其抑菌圈直径介于0.75~1.22 cm, 抑菌带宽介于0.20~0.65 cm, 其中菌株264ZY7对病原菌的拮抗效果强且稳定, 抑菌带宽达到0.65 cm(图1), 说明该菌株具有开发为防治番茄细菌性叶斑病的生物农药的潜力。
2.2.1 形态学鉴定
在NA平板培养基28℃培养3 d后, 264ZY7菌落呈圆形, 边缘锯齿状, 表面光滑, 有光泽, 中央有突起, 米白色, 不透明, 菌落大小约为2 mm(图2)。菌体呈短杆状, 革兰氏染色阳性, 大小为1.534 μ m× 0.571 μ m~3.210 μ m× 0.781 μ m(图3)。
2.2.2 分子生物学鉴定
1) 16S rDNA序列鉴定。经测序得到菌株264ZY7的16S rDNA基因有1460个碱基, 其基因序列在GenBank中与已知序列进行Blast同源性比对, 结果表明, 264ZY7(KF831372)与已报道的解淀粉芽孢杆菌(Bacillus amyloliquefaciens)(HQ840645), 甲基营养型芽孢杆菌(Bacillus methylotrophicus)(HQ662594), 死谷芽孢杆菌(Bacillus vallismortis)(JF496473)和枯草芽孢杆菌(Bacillus subtilis)(JN382471)相似性均达99%, 经建立的系统发育树(图4), 拮抗菌株264ZY7与解淀粉芽孢杆菌(Bacillus amyloliquefaciens)(HQ840645)同源性较近, 初步将其鉴定为解淀粉芽孢杆菌Bacillus amyloliquefaciens。
2) gyrB基因序列鉴定。经测序得到菌株264ZY7的gyrB基因有595个碱基, 其基因序列在GenBank中与已知序列进行Blast同源性比对, 结果表明, 264ZY7(KF831372)与已报道的解淀粉芽孢杆菌(HQ840645)相似性达99%, 经建立的系统发育树(图5)可看出拮抗菌株264ZY7与解淀粉芽孢杆菌(AB829604)聚在一起, 再结合形态学特征和16SrDNA序列分析结果, 将其鉴定为解淀粉芽孢杆菌Bacillus amyloliquefaciens。
菌株264ZY7对番瓜根腐病菌、马铃薯枯萎病菌、黄瓜枯萎病菌的抑菌效果较明显, 抑制率分别为52.84%, 49.60%, 44.97%, 对番茄灰霉病菌、孜然根腐病菌、马铃薯炭疽病菌和小麦根腐病菌抑菌率均在30%以上, 对马铃薯褐腐病菌也有一定的拮抗作用(表1, 图6)。
| 表1 菌株264ZY7的抑菌谱测定 Table 1 The inhibition rate of 264ZY7 against pathogenic fungi |
经盆栽试验, 拮抗菌株264ZY7接种10 d后, 对照的发病率和病情指数分别为94.38%, 55.06%, 拮抗菌处理后的发病率和病情指数分别为54.67%, 17.07%, 拮抗菌株264ZY7对番茄细菌性叶斑病的防效达69%, 说明此拮抗菌对番茄叶斑病有较好的防治效果。
应用拮抗微生物防治细菌性病害在国内外已有大量报道, 如何红等[16]从健康的辣椒植株体内分离筛选出多株对炭疽病、枯萎病等具有较强拮抗和防病作用的内生细菌; 黎起秦等[17]从番茄中分离到对番茄青枯病具有防病效果的内生芽孢杆菌B47(抑菌圈直径0.3 cm); 黄明媛等[18]从番茄根系土壤中分离筛选出4株对番茄青枯病抑菌活性较强的拮抗菌株(抑菌圈0.097~0.330 cm); 李伟杰和姜瑞波[19]也分离筛选出一株对番茄青枯病拮抗作用较强的内生细菌X10(抑菌圈0.104 cm)。内生细菌在植物体内具有稳定的生存空间, 不易受环境条件的影响, 可以在植物体内独立的分裂繁殖和传递, 筛选有益的内生细菌成为生物防治中有潜力的微生物农药、增产菌或作为潜在的生防载体菌而加以利用[20], 本研究从东祁连山高寒草地牧草内分离筛选的内生细菌264ZY7对番茄细菌性叶斑病的抑菌圈直径达到1.22 cm, 抑菌带宽度0.65 cm, 比黎起秦等[17]、黄明媛等[18]、李伟杰和姜瑞波[19]报道的抑菌能力更强。
国内报道了大量有关解淀粉芽孢杆菌防治植物病害的研究, 且多为防治植物病原真菌病害, 如张静等[21]报道了解淀粉芽孢杆菌对山茶灰斑病菌有较好的拮抗作用; 陈士云等[22]研究了一株防治油菜核盘菌(Sclerotinia sclerotiorum)形成的解淀粉芽孢杆菌; 权春善等[23]报道了从堆肥中分离到一株对植物病原菌尖镰刀菌(Fusarium oxysporum)有强烈抑菌活性的解淀粉芽孢杆菌Q12; 赵辉等[24]报道了从芝麻连作田里分离到一株解淀粉芽孢杆菌, 对菜豆壳球孢(Macrophomina phaseolina)、尖孢镰孢菌(Fusarium oxysporum)、多主棒孢霉(Corynespora cassiicola)和芝麻长蠕孢(Helminthosporium sesami)有抑菌活性; 赵晓燕等[25]报道了一株对烟草青枯病菌有一定拮抗作用的解淀粉芽孢杆菌。本研究对菌株264ZY7经形态观察, 并结合分子生物学16S rDNA和gyrB基因序列相似性分析, 鉴定其为解淀粉芽孢杆菌Bacillus amyloliquefaciens, 此外, 该菌株对本实验室内保存的番瓜根腐病菌(抑菌率:52.84%)、马铃薯枯萎病菌(抑菌率:49.60%)和黄瓜枯萎病菌(抑菌率:44.97%)等病原真菌均有良好的拮抗作用, 这与以上报道的解淀粉芽孢杆菌对多种植物病原真菌有较好的拮抗作用结果一致, 本试验中该菌株对细菌性病菌有较好拮抗作用的结果与赵晓燕等[25]报道的结果相符, 且解淀粉芽孢杆菌防治番茄细菌性叶斑病菌在国内首次报道, 但其详细的抑菌机制还有待于进一步探索研究。
赵健等[12]对番茄青枯病的内生拮抗细菌进行室内盆栽防效的测定, 结果表明菌株ZB-6对番茄青枯病的防病效果可达63%~65%, 范晓静等[26]在室内盆栽条件下, 得出内生细菌Fq7对番茄细菌性叶斑病的防病效果达62.71%, 本试验中菌株264ZY7对番茄细菌性叶斑病的盆栽防效达到69%, 说明该菌株对番茄细菌性叶斑病菌有较好的抑制作用, 在微生物农药的开发利用中潜力巨大。但是该生防菌株的作用机理、发酵条件等尚不明确, 还需进一步研究。
The authors have declared that no competing interests exist.
| [1] |
|
| [2] |
|
| [3] |
|
| [4] |
|
| [5] |
|
| [6] |
|
| [7] |
|
| [8] |
|
| [9] |
|
| [10] |
|
| [11] |
|
| [12] |
|
| [13] |
|
| [14] |
|
| [15] |
|
| [16] |
|
| [17] |
|
| [18] |
|
| [19] |
|
| [20] |
|
| [21] |
|
| [22] |
|
| [23] |
|
| [24] |
|
| [25] |
|
| [26] |
|
| [1] |
|
| [4] |
|
| [5] |
|
| [6] |
|
| [7] |
|
| [8] |
|
| [9] |
|
| [10] |
|
| [11] |
|
| [12] |
|
| [13] |
|
| [16] |
|
| [17] |
|
| [18] |
|
| [19] |
|
| [20] |
|
| [21] |
|
| [22] |
|
| [23] |
|
| [24] |
|
| [25] |
|
| [26] |
|